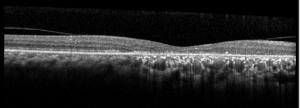

Acute Zonal Occult Outer Retinopathy (AZOOR)
All content on Eyewiki is protected by copyright law and the Terms of Service. This content may not be reproduced, copied, or put into any artificial intelligence program, including large language and generative AI models, without permission from the Academy.
Disease Entity
Disease
Acute zonal occult outer retinopathy (AZOOR) was first described by Donald Gass in 1992; reporting on 13 cases presenting with acute vision loss/visual field defects with photopsias. These patients had acute loss of one or more large zones of outer retinal function with minimal fundus changes at presentation, with some patients having involvement of the blind spot. They demonstrated electroretinographic abnormalities, permanent visual field loss, and delayed development of clinically visible atrophic changes in the retinal pigment epithelium (RPE).[1]
AZOOR has been theorized to be associated with acute idiopathic blind-spot enlargement syndrome (AIBES), multiple evanescent white dot syndrome (MEWDS), acute macular neuroretinopathy (AMN) and other white dot syndromes, as symptoms and findings can overlap; however, this has yet to be clearly determined.[2][3][4][5][6]
Epidemiology
The majority of patients are young females in their mid-thirties[2][4][7] and women have comprised approximately three-quarters of AZOOR cases.[3] AZOOR has been observed in Caucasian patients predominantly; however, the disease has been seen in all ethnic groups.[3][4] Myopia has been a reported association.[8][9]
Pathogenesis
Reduced photoreceptor cell responses on electroretinogram (ERG) testing imply that the abnormalities are centered on the level of the RPE-photoreceptors complex.[7] The choroid has also been implicated as a primary target in AZOOR with possible resulting effect on the RPE-photoreceptors but the initial anatomic target has yet to be determined.[3] The mechanism is unknown at this time but autoimmune causes have been theorized due to the female predominance and susceptibility to develop autoimmune diseases in these patients.[10] Viral infection has also been proposed due to reports of patient’s experiencing viral prodrome with theories of the pathogen entering the retina at the optic nerve head and ora serrata[2] Gass et al. noted that 20% of their 51 patients with AZOOR had an antecedent viral-like illness and 28% had a history of various autoimmune diseases.[5]
In a series by Forooghian et al. evaluating 25 AZOOR patients for antiretinal antibodies, all patients were positive for antiretinal antibodies (average 6.6 bands) on Western blot analysis.[11] Antiretinal antibodies, however, are found in a variety of nonautoimmune retinal diseases and may be isolated in normal individuals; therefore, this association is unclear at this time.[3]
Diagnosis
Symptoms
Patients often note sudden awareness of a scotoma, related to the zone of outer retinal dysfunction, alongside the presence of photopsia (described as “scintillating” or “shimmering” lights). Visual acuity may be decreased. Some patients may report a viral infection preceding the symptoms[5][12]
The disease may progress to involve the second eye. A report of 51 patients followed for a median of 8 years demonstrated that 61% had unilateral involvement at onset; but 76% progressed to bilateral involvement by the final examination. The involvement was delayed by a mean of 50 months.[5]
Signs
Visual acuity is usually minimally affected early in the disease. The anterior chamber is quiet. Vitreous cells may be present but are usually minimal. The fundus initially appears normal followed by retinal atrophy and mottling/mild pigmentary changes of the RPE in the areas involved as the disease progresses. The arterioles may become attenuated.[2][4] [5][6]
Classification
A classification of AZOOR based on clinical fundus and multimodal imaging was proposed[13]:
Diagnostic Procedures
Visual Field Testing
A wide variety of visual field defects may be observed. The most common presentation observed has been an enlargement of the blind spot which may be associated with central/paracentral scotomas.[4][5][10]
In a study of 32 Japanese patients with AZOOR, the baseline to 6-month mean deviation (MD) value increased by 30% in the majority (71.9%) of the patients; none showing a worsening of 30% or more. The MD values at the final visit (median of 31 months) increased by 30% in 63.2%, remained unchanged in 34.2%, and decreased by 30% or more in 2.6% of the patients.[8]
Optical Coherence Tomography (OCT)
OCT findings in AZOOR are characterized by the loss of outer retinal segments in one or more extensive zones.[14] In almost all patients with AZOOR and AIBSE, spectral-domain OCT reveals abnormalities involving the ellipsoid zone or interdigitation zone.[3] Chronically, atrophy of the RPE and thinning of the retina may be seen in the outer nuclear layer followed by thinning of the inner nuclear layer.[2][13] A trizonal appearance can also be seen on OCT. Testing was normal outside the AZOOR line (zone1). Inside the AZOOR line, multifocal material was present in the subretinal space (zone 2). Photoreceptor, RPE and choroidal atrophy are evident in zone 3).[13]
Fundus Autofluorescence (FAF)
FAF is extremely useful in defining the areas of retinal involvement and monitor for signs of progression.[15][16] FAF documents the presence and distribution of lipofuscin in the RPE cells; a decrease in autofluorescence indicates loss or damage to the RPE cells with hyperautofluorescence indicating increased metabolic activity.[16]
Mrejen et al describe a trizonal defect appearance on FAF, correlating to the similar trizonal pattern observed on OCT. Normal autofluorescence can be observed in the area outside of the delineating line (zone 1), speckled hyperautofluorescence could be seen within the AZOOR lesion (zone 2), and hypoautofluorescence was present indicating RPE/choroidal atrophy (zone 3).[13]
Fundus Fluorescein Angiography (FFA)
Initially fluorescein angiography may demonstrate normal findings with window defects and staining of the RPE as the disease progresses.[2][4]Peripapillary hyperfluorescence has been reported with optic nerve staining.[3]
Indocyanine Green Angiography (ICG)
May appear normal or show hypofluorescence in the area involved.[2][4] Late stage AZOOR may also show a trizonal pattern on ICG. Outside of the AZOOR lesion was a normal zone (zone 1). Inside the AZOOR line, minimal late extrachoroidal leakage was present (zone 2). Hypofluorescence with the absence of leakage corresponding to choriocapillaris atrophy represents zone 3.[13]
A representative case has been presented at http://westcoastretina.com/july-2012.html
Electrophysiology
ERG is nearly always abnormal in AZOOR and tends to show a delay in the cone system e.g delayed implicit time of the 30-Hz cone flicker response. Although there is a localized retinal dysfunction, ERG has been observed to be globally affected on full-field testing.[10] [17] A multifocal ERG will tend to show depressed responses that correspond with visual field defects.[3]
On the electro-oculogram (EOG), a reduction in the light rise may be present.[2][4] EOG is not frequently utilized in AZOOR given the classic findings seen above.
Adaptive Optics
Zones of cone photoreceptor loss with attenuation of ellipsoid zone and loss of interdigitation zone has been observed on adaptive optic-OCT imaging in some studies [18]
Differential diagnosis
An understanding of the multimodal imaging findings and presenting symptoms as outlined above may prevent costly and potentially invasive work-up for other conditions. Below are considerations in the differential diagnosis for photopsias, visual field defects/scotomas, and/or retinal pigmentary changes:
- Autoimmune Retinopathy
- Cancer-associated retinopathy
- Melanoma associated retinopathy
- Non-neoplastic autoimmune retinopathy
- White Dot Syndromes
- Multiple Evanescent White Dot Syndrome (MEWDS)
- Punctate Inner Choroidopathy (PIC)
- Multifocal Choroiditis and Panuveitis (MCP)
- Acute Macular Neuroretinopathy (AMN)
- Acute Posterior Multifocal Placoid Pigment Epitheliopathy (APMPPE)
- Birdshot Chorioretinopathy
- Serpiginous Choroidopathy
- Acute Idiopathic Enlarged Blindspot Syndrome (AIEBS)
- Idiopathic optic neuritis
- Inflammatory and Infectious optic neuropathies
- Infection
- Syphilis
- Diffuse Unilateral Subacute Neuroretinitis (DUSN)
- Presumed Ocular Histoplasmosis (POHS)
- Human Immunodeficiency Virus
- Cone, Cone-rod dystrophies
- Toxic Retinopathies
- Sectoral Retinitis Pigmentosa
- Resolved Retinal Detachment
- Neurologic causes of scotomas and scintillations e,g compressive lesions, migraine aura
Systemic Associations
Systemic autoimmune diseases have been noted in some patients with AZOOR. The most commonly associated immune-mediated diseases include Hashimoto's thyroiditis, Graves’ disease, hypothyroidism, multiple sclerosis, Addison's disease, myasthenia gravis, insulin-dependent diabetes mellitus, CREST syndrome, Sjögren’s disease, and Crohn disease.[2][4][5]
Management
Medical therapy
No proven treatment exists. Systemic corticosteroids, immunosuppressive drugs (cyclophosphamide, methotrexate, azathioprine, etc.), antiviral (acyclovir and valacyclovir) and antibacterial (sulfadiazine and trimethoprim) medications have been tried with no consensus on the success.[3][4] Spontaneous remission has also been observed.[19]
Indeterminate improvements in vision and on ophthalmic imaging/testing have been reported following varying regimes of intravenous and oral corticosteroids with tapering regimes but larger studies with control groups are needed.[8][20][21] In a study by Barnes et al, 9 eyes were treated with intravitreal steroid injections or implants and observed stable or improved vision.[22] There are cases reported of disease reactivation following prednisone tapers requiring steroid-sparing immunosuppressant therapy.[21]
Prognosis
Due to the rarity of AZOOR, it is difficult to characterize the progression and prognosis of this disease and the clinical course can be variable. Visual field defects tend to be permanent.[8][23][24] Stabilization has been reported to have occurred within 6 months in the majority of patients (77-90%) after the initial progressive decline early in the disease.[4][5] Saito et al. also found in their study of 32 Japanese patients that the visual field parameters stabilized at 6 months, with only 2.6% continuing to worsen at the final visit (median of 31 months).[8]
However, there is significant variability in the literature. Hoang et al report a case of a 55-year-old female patient followed-up for thirteen years who despite treatment attempts with acyclovir and immunomodulatory drugs (periocular and systemic steroids, and cyclosporine) demonstrated no change in the progression with severe visual field constriction secondary to diffuse chorioretinal atrophy.[23]
References
- ↑ Gass JD. Acute zonal occult outer retinopathy. Donders Lecture: The Netherlands Ophthalmological Society, Maastricht, Holland, June 19, 1992. J Clin Neuroophthalmol. 1993;13:79-97
- ↑ 2.0 2.1 2.2 2.3 2.4 2.5 2.6 2.7 2.8 Ryan, Stephen. Retina. 5th Ed. China: El Sevier Saunders, 2013:1368-1371
- ↑ 3.0 3.1 3.2 3.3 3.4 3.5 3.6 3.7 3.8 Fletcher WA, Imes RK. Acute Idiopathic Blind Spot Enlargement and Acute Zonal Occult Outer Retinopathy: Potential Mimics of Neuro-Ophthalmic Disease. J Neuroophthalmol. 2020 Sep;40 Suppl 1:S43-S50
- ↑ 4.00 4.01 4.02 4.03 4.04 4.05 4.06 4.07 4.08 4.09 4.10 Monson D, Smith J. Acute Zonal Occult Outer Retinopathy. Surv Ophthalmol 2011;56:23-35
- ↑ 5.0 5.1 5.2 5.3 5.4 5.5 5.6 5.7 Gass JD, Agarwal A, Scott I. Acute Zonal Occult Outer Retinopathy: A Long-term Follow-up Study. Am J Ophthalmol 2002;134:329-339
- ↑ 6.0 6.1 Gass JD. Are acute zonal occult outer retinopathy and the white spot syndromes (AZOOR complex) specific autoimmune diseases? Am J Ophthalmol 2003;135:380-381
- ↑ 7.0 7.1 Jakobiec, Albert. Principles and Practice of Ophthalmology, 3rd Ed, Vol #2. Edinburgh, Saunders; 2008:2071-2072
- ↑ 8.0 8.1 8.2 8.3 8.4 Saito S, Saito W, Saito M, Hashimoto Y, Mori S, Noda K, et al. Acute Zonal Occult Outer Retinopathy in Japanese Patients: Clinical Features, Visual Function, and Factors Affecting Visual Function. PLoS ONE 2015;10(4)
- ↑ Matsui Y, Matsubara H, Ueno S, Ito Y, Terasaki H, Kondo M. Changes in outer retinal microstructures during six month period in eyes with acute zonal occult outer retinopathy-complex. PLoS One. 2014;9:e110592
- ↑ 10.0 10.1 10.2 Pellegrini F, Cirone D, De Simone L, Marullo M, Cimino L. Acute zonal occult outer retinopathy complex disease: Lessons learned about choroid, photoreceptors, and retinal function. Eur J Ophthalmol. 2021 Jan 9:1120672120986376.
- ↑ Forooghian F. Prevalence of Antiretinal Antibodies in Acute Zonal Occult Outer Retinopathy: A Comprehensive Review of 25 Cases. Am J Ophthalmol. 2017 Jul;179:210-211
- ↑ Agarwal, Anita. Gass’ Atlas of Macular Diseases, 5th Ed. China: El Sevier Saunders; 2012: 980-983
- ↑ 13.0 13.1 13.2 13.3 13.4 Mrejen S, Khan S, Gallego-Pinazo R, Jampol L, Yannuzzi L. Acute Zonal Occult Outer Retinopathy A Classification Based on Multimodal Imaging. JAMA Ophthalmol 2014;132(9):1089-1098
- ↑ Guijarro A, Muñoz N, Alejandre N, Recuero S, Sanchez-Pernaute O, Carreño E. Long term follow-up and effect of immunosuppression in acute zonal occult outer retinopathy. Eur J Ophthalmol. 2020
- ↑ Ryan, Stephen. Retina. 5th Ed. China: El Sevier Saunders, 2013:1368-1371
- ↑ 16.0 16.1 Fujiwara T, Imamura Y, Giovinazzo V, Spaide R. Fundus Autofluorescence and Optical Coherence Tomographic Findings in Acute Zonal Occult Outer Retinopathy. Retina 2010;30:1206-1216
- ↑ Francis PJ, Marinescu A, Fitzke FW, Bird AC, Holder GE. Acute zonal occult outer retinopathy: towards a set of diagnostic criteria. Br J Ophthalmol 2005;89:70-73
- ↑ Xu QA, Athwal A, Heisler M, Ju MJ, Vanzan V, Ferrara D, Sarunic M, Navajas EV. Adaptive Optics Optical Coherence Tomography In A Case Of Acute Zonal Occult Outer Retinopathy. Retin Cases Brief Rep. 2020 Apr 7.
- ↑ Nakao S, Kaizu Y, Yoshida S, Iida T, Ishibashi T. Spontaneous remission of acute zonal occult outer retinopathy: follow-up using adaptive optics scanning laser ophthalmoscopy. Graefes Arch Clin Exp Ophthalmol 2015;253:839-843
- ↑ Kitakawa T, Hayashi T, Takashina H, Mitooka K, Gekka T, Tsuneoka H. Improvement of central visual function following steroid pulse therapy in acute zonal occult outer retinopathy. Doc Ophthalmol 2012;124:249-254
- ↑ 21.0 21.1 Chen SN, Yang CH, Yang CM. Systemic corticosteroids therapy in the management of acute zonal occult outer retinopathy. J Ophthalmol 2015;2015:793026
- ↑ Barnes A, Lowder C, Bessette A, Baynes K, Srivastava S. Treatment of acute zonal occult outer retinopathy with intravitreal steroids. Ophthalmic Surg Lasers Imaging Retina. 2018;49:504-509.
- ↑ 23.0 23.1 Hoang Q, Gallego-Pinazo R, Yannuzzi L. Long-term follow-up of acute zonal occult outer retinopathy. Retina 2013;33:1325-1327
- ↑ Smith-Hansen P, Gazieva L, Ilginis T. AZOOR - A 10-year follow-up. Acta Ophthalmol. 2016 Aug;94(5):e379-80.